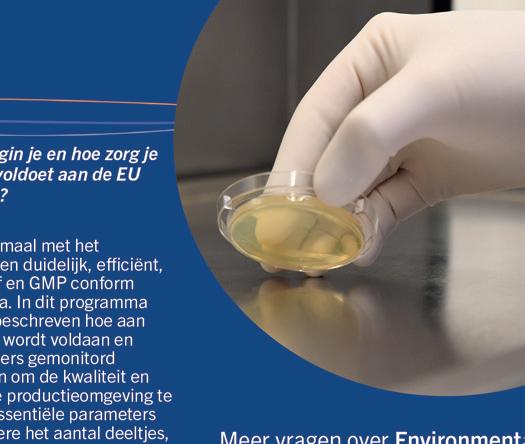

HET PROGRAMMA VAN EISEN
VOOR EEN NIEUWE CLEANROOM


HOOGWAARDIGE




NIEUWE CLEANROOM INDUSTRIE:
MODERNE EISEN AAN






‘FIELD OF VIEW’













![]()























HET PROGRAMMA VAN EISEN
VOOR EEN NIEUWE CLEANROOM


HOOGWAARDIGE




NIEUWE CLEANROOM INDUSTRIE:
MODERNE EISEN AAN






‘FIELD OF VIEW’













Welkom bij deze nieuwe editie van het VCCN Contamination Control Magazine. Terwijl de nazomer langzaam plaatsmaakt voor de herfst, nemen we je graag mee in de wereld van cleanrooms en contamination control een wereld waarin elk detail telt.
Want wij, met zijn allen, bevinden ons echt in een bijzondere industrie die het verschil maakt in de wereld. Zonder cleanrooms zouden veel technologische en maatschappelijke doorbraken simpelweg niet mogelijk zijn.
• Kunstmatige intelligentie (AI) lijkt misschien vooral een softwareverhaal, maar de chips en halfgeleiders die het mogelijk maken, worden uitsluitend geproduceerd in de schoonste omgevingen ter wereld.
• De energietransitie vraagt om hoogwaardige batterijen met extreme performance en betrouwbaarheid en die kunnen alleen ontwikkeld en geproduceerd worden in gecontroleerde, stofvrije omgevingen.
• Ook de gezondheidszorg leunt op cleanrooms: van innovatieve medicijnen en vaccins tot medische hulpmiddelen en implantaten, allemaal ontstaan ze in een omgeving waar contaminatie nagenoeg geen kans krijgt.
Alle hierboven genoemde aspecten zijn een seculaire trend, want deze worden wereldwijd gezien als bepalend voor de komende decennia. En juist cleanrooms en alles eromheen, dus ook dit vakgebied, vormt de stille en onmisbare motor achter die vooruitgang. We hebben als redactie ons best gedaan om weer een editie vol kennis en inspiratie samen te stellen. Aan jou om te oordelen of dit is gelukt.
Ik wens je veel leesplezier en alvast een mooie, kleurrijke herfst toe!
Arthur Lettinga Hoofdredacteur VCCN Contamination Control Magazine


CoreDux heeft recentelijk zijn cleanroomoppervlak verdrievoudigd met de opening van een nieuwe cleanroom. In dit artikel delen we de highlights uit ons Programma van Eisen (PvE), waarin tien jaar ervaring als cleanroomgebruiker in de Semicon-, Aeronautics & Defence-, Space-, High Tech- en New-Energy-markten is meegenomen.
Door: Mark Leenen, CoreDux Netherlands B.V.

NIEUWE CLEANROOM INDUSTRIE: BATTERIJPRODUCTIE
De wereld elektrificeert in rap tempo. Van smartphones en laptops tot elektrische voertuigen en grootschalige energieopslag: de vraag naar krachtige en betrouwbare batterijen groeit explosief. Lithium-ionbatterijen spelen hierin een sleutelrol dankzij hun hoge energiedichtheid, lange levensduur en brede toepasbaarheid. Cleanrooms zijn essentieel bij de productie van batterijen omdat de productie van lithium-ionbatterijen hoge eisen stelt aan de omgeving om contaminatie te minimaliseren. Een cleanroom omgeving kan een significante bijdrage leveren aan de kwaliteit, de performance en de levensduur van een batterij.
Door: Arthur Lettinga, Elis Cleanroom

MODERNE EISEN AAN HOOG
WAARDIGE UV INSPECTIELAMPEN
Innovatie in de halfgeleiderindustrie ontwikkelt zich in een ongekend tempo. Chips worden steeds krachtiger en complexer, terwijl de wereldwijde vraag naar hoogwaardige microchips blijft gestaag toenemen. Om de benodigde reinheid te bereiken zijn geavanceerde inspectietechnologieën, zoals UV-A belichting in cleanroomomgevingen essentieel.
Door: Ronald van Lierop* en Guud Staaltjens**, *Alcochem Hygiene Nederland, **Romex B.V.

Ons gezichtsveld kan worden onderverdeeld in een centraal en perifeer gedeelte. Bij het gebruik van veiligheidsbrillen of andere persoonlijke beschermingsmiddelen (PBM) voor het gezicht en meer specifiek rond de ogen zal dit veelal ons gezichtsveld, ook wel “Field of View” of FoV genoemd, verkleinen. Een kleinere FoV kan, via een vermindering van onze visuele capaciteiten, een negatief effect hebben op handelingen die moeten worden uitgevoerd.
Door: Hugo Corstjens, Consulent in health & beaty - founder of Novigo+ en Stefaan Vanhalle, R&D Manager STAXS®
6 HET PROGRAMMA VAN EISEN VOOR EEN NIEUWE CLEANROOM
Door: Mark Leenen, CoreDux Netherlands B.V.
12 NIEUWE CLEANROOM
INDUSTRIE: BATTERIJPRODUCTIE
Door: Arthur Lettinga, Elis Cleanroom
20 MODERNE EISEN AAN HOOGWAARDIGE
UV INSPECTIELAMPEN
Door: Ronald van Lierop* en Guud Staaltjens**, *Alcochem Hygiene Nederland, **Romex B.V.
24 ‘FIELD OF VIEW’ VAN VEILIGHEIDSBRILLEN NADER BESCHOUWD
Door: Hugo Corstjens, Consulent in health & beauty - founder of Novigo+ en Stefaan Vanhalle, R&D Manager STAXS®
30 NIEUW: DE CLEANROOM BEWEEG TRAINING
Door: Jos Bijman, Kennismanager VCCN
34 CURSUS UITGELICHT
Post-hbo opleiding Contamination Control & Cleanliness
37 EEN DAG UIT HET LEVEN VAN... Bram Mensink, Innovatiemanager bij Asito
40 CURSUSSEN 2025/2026 / EVEN VOORSTELLEN









CoreDux heeft recentelijk zijn cleanroomoppervlak verdrievoudigd met de opening van een nieuwe cleanroom. In dit artikel delen we de highlights uit ons Programma van Eisen (PvE), waarin tien jaar ervaring als cleanroomgebruiker in de Semicon, Aeronautics & Defence, Space, High Tech en NewEnergymarkten is meegenomen. Het belang en het gebruik van een voldoende gedetailleerd PvE wordt besproken, waarbij wordt ingegaan op de diverse aspecten die van belang zijn om genoemd te worden in een PvE.





In de Cleanroom Techniek Cursus van VCCN leer je als deelnemer vanuit een maakbedrijf hoe je een technisch Programma van Eisen (PvE) opstelt voor een nieuwe of te verbouwen cleanroom. Een gedetailleerd PvE is onmisbaar in het tenderproces: cleanroomontwerpers en -bouwers kunnen op basis van het PvE een zo nauwkeurig en scherp mogelijke aanbieding doen. Verrassingen achteraf worden voorkomen met een geschikt detailniveau van het PvE, en aanbieders vinden in het PvE natuurlijk ook haakjes om op te beargumenteren waarom zij de beste partij zijn om mee in zee te gaan. Het keuzeproces tussen de verschillende aanbieders wordt vergemakkelijkt, en later in het traject zijn er minder ontwerpiteraties nodig, waardoor de totale doorlooptijd van eerste gesprekken tot eindoplevering met een goed PvE duidelijk verkleind wordt.
Contaminatiebeheersing is dé reden om maakprocessen in een cleanroom uit te voeren en niet in een reguliere fabriekshal. Maar ook in een cleanroom is contaminatiebeheersing van belang om de integriteit van de cleanroom te waarborgen. Daarom is contaminatiebeheersing een belangrijke pijler in een PvE voor een cleanroom.
Vuistregel: alles wat niet in de cleanroom móét zijn, hoort er ook niet. Dat geldt voor mensen, processen én voor steeds meer elementen hoe verder je met een PvE aan de slag gaat. Onderhoud aan machines vormt een contaminatierisico: denk aan smeermiddelen, of vervanging van filters bij reinigingsbaden. Wanneer (delen van) machines in de buitenwand of zelfs helemaal buiten de cleanroom geplaatst kunnen worden (zoals een extern filtratiecircuit), kan ook onderhoud daaraan buiten de cleanroom plaatsvinden. En wellicht is de koeling van zo’n machinekamer dan wel te combineren met een overstort uit het plenum van de cleanroom. Wat zegt het PvE over de benodigde koelcapaciteit in die machinekamer?
Onderhoud is ook mede bepalend geweest voor een van de basiskeuzes: een plenum met beloopbaar plafond. Zeker wanneer een cleanroom langere tijd in gebruik is, zal er regelmatig onderhoud nodig zijn aan de verlichting en aan de luchtbehandeling. Dan is het een groot voordeel wanneer men de keuze heeft om onderhoud van bovenaf uit te voeren, vanuit het plenum, in plaats van op een ladder of hoogwerker (maak die eerst maar eens schoon...) in de cleanroom.
Bovendien is het contaminatierisico zeer laag bij tijdelijke openingen tussen plenum en cleanroom, bijvoorbeeld wanneer er een LED-lamp of plafondpaneel vervangen moet worden. Zonder plenum zou je dan eerst de cleanroom plaatselijk leeg moeten maken of tenminste afdekken, omdat er een directe breach richting de fabriekshal plaats zal vinden tijdens dit onderhoud. Nadien moet de cleanroom grondig schoongemaakt worden.
Dat betekent een significante downtime voor de productielocatie, en in geval van een plotseling optredend defect, ook nog eens ongepland.
Het naar wens kunnen verplaatsen van plafondpanelen, bijvoorbeeld met
gasaansluitingen, biedt bovendien flexibiliteit om productielijnen aan te passen wanneer dat nieuwe klantvragen helpt te realiseren.
Correctief onderhoud kan gefaciliteerd worden met sensoren die kritische onderdelen live monitoren. Denk aan een drukvalmeting over een inblaasfilter, die een seintje geeft wanneer de filters vervangen moeten worden. Of slimme systemen in de luchtbehandeling die regelmatig of continu een zelfdiagnose doen en eveneens een seintje geven wanneer er iets niet klopt.
MATERIAALGEBRUIK
Natuurlijk worden er alleen bouwmaterialen gebruikt die geschikt zijn voor toepassing in een cleanroom van de benodigde classificatie. De ontwikkelingen in de markt gaan snel; verken daarom samen met de cleanroomontwerpers de laatste stand van techniek in cleanroombouwmaterialen. De beste materialen genereren weinig tot ‘geen’ deeltjes, zijn makkelijk schoon te houden, slijtvast, hebben een lage uitgassing en mogelijk gelden er nog meer eisen (chemische bestendigheid). En hoe ver zijn de cleanroombouwers in het circulair bouwen?
OMKLEEDRUIMTEN
Kluisjes van medewerkers en de tijdelijke opslag van gebruikte cleanroomkleding voor bewassing zijn bewust uit de personensluis (PAL) gelaten en geplaatst in de buitenwand van de cleanroom, direct naast de ingang van de PAL.

Afbeelding 1: Een werkstation met laskop en afzuiging.
Regelmatig is er overleg nodig tussen medewerkers die binnen en buiten de cleanroom werken. Dit is gefaciliteerd met intercoms in de binnen- en buitenwand van de cleanroom, naast een raam zodat de medewerkers die met elkaar spreken, elkaar ook kunnen zien. Zo wordt voorkomen dat medewerkers mét en zonder cleanroomkleding in een sluis moeten afspreken om te overleggen. Daarmee wordt een belangrijk contaminatie -
mechanisme voor cleanroomkleding geëlimineerd.
Een zeer geschikte methode om de reinheid van werkplekken te inspecteren, is met UV-licht. Daarvoor is wel een donkere omgeving nodig, maar alleen op de werkplek die geïnspecteerd moet worden; de verlichting in de overige cleanroom ruimtes moet dan aan blijven zodat het werk daar door kan gaan. Het heeft grote
GELDEN ER NOG MEER EISEN (CHEMISCHE BESTENDIGHEID).
waarde om in iedere sub-ruimte in de cleanroom ook lokaal de verlichting te kunnen schakelen, om UV-inspectie van werkplekken in iedere sub-ruimte te faciliteren. Voor productvalidatie met UVinspectie is uiteraard een ruimte nodig waarin het luxniveau in donkere toestand in het PvE is vastgelegd.
Contaminatiebeheersing begint overigens al tijdens de bouw van de cleanroom. Spreek met de aannemer af dat de bouwplaats vanaf de eerste dag schoon en opgeruimd is en blijft, en vanaf welk moment de cleanroom alleen nog maar in (gedeeltelijke) cleanroomkleding betreden mag worden. Vlak voor de validatie en de eindoplevering wordt natuurlijk een grondige totaalschoonmaak georganiseerd.
Met schetsontwerpen wordt begonnen om te bepalen hoe groot de cleanroom moet zijn. Daarbij moeten diverse vragen worden beantwoord:
• Welke workflows moeten erdoorheen lopen, langs welke werkstations?
• Welke productievolumes moet deze cleanroom, ook over enkele jaren aan kunnen?
• Welke subruimtes zijn er nodig, met welke classificaties?
• Welke procesmedia (demiwater, verschillende gassen, maar ook afzuiging) zijn er nodig op welke werkplek?
• Welke hoogte staat de fabriekslocatie toe, of welke hoogte is er nodig voor het productieproces?
• Hoe behouden we flexibiliteit om de cleanroom in de toekomst opnieuw in te kunnen delen of uit te breiden? En kan dan bijvoorbeeld het meubilair in de personensluis wel meegroeien?
• Hoe willen we het oppervlak op het entresol (in de toekomst) nog verder inzetten?
Met schetsen kun je hierin al een heel eind komen, zeker als onderdeel van het PvE. Later in de ontwerpfase verdient het een sterke aanbeveling om met behulp van 3D-ontwerpen de laatste belangrijke keuzes te maken. In zo’n 3D-ontwerp wordt het bijvoorbeeld snel duidelijk wanneer luchtbehandeling, gasleidingen, sprinklerleidingen, condensafvoer en kabelgoten elkaar in de weg dreigen te gaan zitten.

Bovendien komt de cleanroom in een 3D-ontwerp al veel meer tot leven.
Toekomstige maakprocessen en het transport van mensen en goederen kan in 3D-ontwerpen nog beter worden voorgesteld dan in 2D-ontwerpen, waardoor nieuwe inzichten opgedaan kunnen worden en het ontwerp nog aangepast kan worden. In het PvE kan opgenomen worden dat de “final GO” wordt gegeven op basis van allesomvattende 3D-ontwerpen.
Door energiebesparing op te nemen in het PvE worden cleanroomontwerpers uitgedaagd om een zo energiezuinig mogelijk ontwerp te maken. Dat uiteraard nog wel voldoet aan alle overige functionele eisen. Een cleanroom met plenum heeft al gauw tientallen fan filter units (FFU’s) draaien; het loont om in de basis te kiezen voor energiezuinigere FFU’s. Bovendien hoeven die FFU’s niet voltijd op vol vermogen te draaien. In de nacht en het weekend kan de luchtbehandeling van de cleanroom verantwoord op een lagere luchtverversingsgraad gehouden
worden, wanneer er niet gewerkt wordt. Al wil je wel de flexibiliteit om een nachtof weekenddienst te draaien, wanneer dat nodig is.
In een cleanroom worden temperatuur en luchtvochtigheid gereguleerd via de luchtbehandeling. In ruimtes waarin gevoelige processen draaien, is een precieze regulering vereist, maar dat geldt niet voor alle subruimtes in de cleanroom. In sommige ruimtes kunnen de regelgrenzen wellicht opgerekt worden, met energiebesparing als gevolg. Je zult altijd de mogelijkheid willen hebben om de lucht in de cleanroom te drogen. Maar is voor ieder subplenum een stoombevochtiger nodig, of kan die in sommige gevallen uit het ontwerp worden gelaten?
Wanneer er geen of weinig mensen in de cleanroom aanwezig zijn, hoeft de luchtbehandeling minder hard te werken om de gewenste ISO-klasse te handhaven. Op zulke momenten kun je het aantal luchtwisselingen verlagen en toch compliant blijven. Deeltjestellers kunnen live het aantal deeltjes in de cleanroomlucht
Ben je bezig met het ontwerpen of bouwen van een cleanroom?
Dan is de VCCN Cleanroom Techniek Cursus precies wat je nodig hebt.
Deze cursus stelt je in staat om een goede afweging te maken van alle belangrijke facetten bij het opzetten van een cleanroom. Deze cursus leert je een compleet ‘Programma van Eisen’ op te stellen voor een cleanroom. Je dient na afronden van de cursus een procesanalyse te kunnen maken, nodig voor het bepalen van de benodigde ruimten, classificatie en indeling.
Het unieke van deze cursus is dat ontwerpers, bouwers én toekomstige gebruikers samen les krijgen. Zo leer je niet alleen van docenten, maar ook van elkaar.
Startdatum: 30 september
bekijk www.vccn.nl voor meer informatie.
monitoren en binnen gegeven regelgrenzen, de luchtbehandeling bijsturen.
Dat betekent: minder luchtwisselingen bij lage deeltjesaantallen en een dynamische verhoging van het aantal luchtwisselingen zodra er een toename wordt gemeten.
Dit kan per sub-zone ontworpen worden. Daarbij is het logisch om de meest contaminatie-kritische werkplekken te monitoren, dan wel om de FFU’s aan te sturen die juist het vaakst met een laag debiet kunnen draaien.
Ook de toevoer van verse lucht kan slim gebeuren, als respons op concentraties CO2 in de cleanroom in plaats van een vast debiet. Wanneer de lucht in de omringende fabriekshal overigens geschikt is als ‘verse lucht’, verdient dit qua energiegebruik sterk de voorkeur boven directe aanvoer van buitenlucht. Die varieert namelijk sterk in temperatuur en luchtvochtigheid, wat allemaal weggeregeld moet worden voordat de lucht dieper de cleanroom in gebracht wordt.
Met een gedetailleerd PvE haal je als opdrachtgever het beste naar boven bij de cleanroomontwerpers. Daarnaast faciliteert een dergelijk PvE het tenderproces, wat bijdraagt aan een zo kort mogelijke doorlooptijd van eerste gesprekken tot oplevering. Energiebesparing is onontbeerlijk in een PvE anno 2025, naast uiteraard contaminatiebeheersing in al zijn facetten. En daag de organisatie uit om enkele jaren vooruit te denken; welke processen moeten we over 3 jaar kunnen draaien in deze cleanroom, en welke extra eisen vloeien daaruit voort?
[1] VCCN Cleanroom Techniek cursus en syllabus, 2023 CoreDux® expands its production capacity in Tilburg - CoreDux

















De wereld elektrificeert in rap tempo. Van smartphones en laptops tot elektrische voertuigen en grootschalige energieopslag: de vraag naar krachtige en betrouwbare batterijen groeit explosief. Lithiumionbatterijen spelen hierin een sleutelrol dankzij hun hoge energiedichtheid, lange levensduur en brede toepasbaarheid.
Cleanrooms zijn essentieel bij de productie van batterijen omdat de productie van lithiumionbatterijen hoge eisen stelt aan de omgeving om contaminatie te minimaliseren. Een cleanroom omgeving kan een significante bijdrage leveren aan de kwaliteit, de performance en de levensduur van een batterij.





Als we kijken naar de afgelopen jaren in ons leven, dan zie je dat veel zaken behoorlijk zijn veranderd en dan met name op het gebied van elektriciteit. Om maar een aantal voorbeelden te noemen: we koken vaker elektrisch, we hebben zonnepanelen op onze daken, we fietsen elektrisch en we rijden steeds vaker in elektrische auto’s. Uiteraard is hier nog heel veel terrein te winnen en ondanks dat is er al behoorlijk wat groei gerealiseerd. Deze groei zal alleen nog maar meer gaan doorzetten, want ik geloof ook dat we in de toekomst meer gaan doen met energieopslag, zodat alle opgewekte energie later opnieuw kan worden gebruikt (denk aan een thuis batterij). Dit belooft wederom een expotentiële groei te zijn binnen de productie van batterijen. Een van de speerpunten voor het succes van een goede batterij is de levensduur en die kan gemaximaliseerd worden door in het productieproces verstorende factoren buiten te houden. Laat dit nou net de functie zijn van een cleanroom.
Uit onderzoek blijkt dat de Europese batterijproductie naar verwachting 238 GWh zal bereiken in 2025, 413 GWh in 2027 en 773 GWh in 2030. Ter vergelijking: in 2022 was dit nog 69 GWh. Deze capaciteit omvat projecten die vergevorderde financieringsen bouwvergunningsfasen hebben. Nu er echter nog veel nieuwere projecten in uitvoering zijn, is de potentiële capaciteit zelfs

Afbeelding 1: Fabricage lithium-ionbatterij voor e-auto.
nog groter: 286 GWh in 2025, 616 GWh in 2027 en 1.395 GWh in 2030 als alle projecten volgens plan verlopen [1]
Deze groei wordt gedreven door de toenemende vraag naar lithium-ionbatterijen, welke vaak worden gebruikt in consumentenelektronica, elektrische voertuigen (EV's), en energieopslagsystemen. De reden dat deze vaak worden toegepast is vanwege hun hoge energiedichtheid en lange levensduur.
Cleanrooms zijn essentieel in de batterijproductie omdat de productie van lithium-ionbatterijen hoge eisen stelt aan de reinheid en controle van de omgeving om defecten en verontreinigingen te minimaliseren. Cleanrooms zorgen voor de juiste omstandigheden voor de fabricage van hoogwaardige batterijen, wat bijdraagt aan de algehele efficiëntie en kwaliteit van de productie.
De lithium-ionbatterij is opgebouwd uit de volgende componenten:
• Anode (negatieve elektrode): vaak gemaakt van grafiet.

Afbeelding 2: Opbouw van een lithium-ionbatterij.
• Kathode (positieve elektrode): vaak gemaakt van lithium-metaaloxiden, zoals bijvoorbeeld lithium-kobaltoxide (LiCoO2) of lithium-mangaanoxide.
• Elektrolyt: een vloeibare oplossing die lithium-ionen bevat en zorgt voor transport van ionen tussen de anode en de kathode.
• Separator: een dunne membraan die de anode en kathode fysiek gescheiden houdt om kortsluiting te voorkomen, maar ionen wel doorlaat.
Tijdens het ontladen bewegen lithiumionen van de anode naar de kathode door de elektrolyt en genereren ze een elektrische stroom. Tijdens het opladen keren de ionen terug naar de anode [2]
IONBATTERIJ
Batterijen zijn erg gevoelig voor vocht en dit kan een grote impact hebben op het resultaat van de productie (yield = percentage foutloze producten) en de levensduur van een batterij. Daarom vindt de fabricage van batterijen plaats in zogenoemde dry rooms, waarin de luchtvochtigheid lager is dan 5% relatieve luchtvochtigheid. De meeste van deze ruimtes zijn daarnaast ook cleanrooms van klasse 6 of klasse 7.
Cleanrooms zijn primair gericht op het beheersen van het aantal deeltjes in de lucht. Droge ruimtes daarentegen richten zich bijna uitsluitend op het verlagen van de luchtvochtigheid, wat cruciaal is voor vochtgevoelige materialen.
Voor de productie van batterijen in droge ruimtes en cleanrooms hebben operators kleding nodig die lintvrij, antistatisch en bestand zijn tegen mogelijke blootstelling aan chemicaliën en als zodanig ook de reinheid van de cleanroomomgeving in stand houden. Het is dus uiterst belangrijk om de omgevingseisen en de gevaren per ruimte in kaart te brengen om voor zowel product als operator de juiste maatregelen te treffen.
Voor de productie van batterijen worden cleanrooms van ISO-klasse 6 vereist, onder andere bij de productie van elektroden (coaten, drogen, calenderen) en bij de celassemblage, inclusief celafdichting (Rudolph, 2013) [3]
PROCESSTAPPEN IN DE PRODUCTIE VAN BATERIJEN
Hieronder staan de elf belangrijkste processtappen die over het algemeen gelden voor het producten van baterijen:
1. Mixen
De eerste processtap in de productie van batterijcellen is de productie van de zogenaamde slurry. Dit bestaat uit de afzonderlijke grondstoffen voor de elektrode (actief materiaal, bindmiddel en oplosmiddel en geleidende additieven). De eigenschappen van de slurry zijn aanzienlijk niet alleen beïnvloed door het niveau van de toegepaste energie en de procestemperatuur maar ook het recept volgorde die wordt gebruikt om actief en passief toe te voegen materialen in een nat of droog mengproces (Kaiser, 2014) [4]
2. Coating
De hiervoor geproduceerde slurry wordt aangebracht op een dunne folielaag van koper of aluminium. Dit wordt uitgevoerd door een coatingmachine. Dit is dus een anode-slurry of een kathode-slurry.
3. Drogen
In deze processtap wordt vocht of oplosmiddel uit de slurry ontrokken, waardoor
de elektrode overblijft. Temperatuur en druk moeten hierbij goed afgesteld worden om niet een gevaar te vormen voor de uiteindelijke werking van de elektrode.
4. Calendering
In deze machine worden de elektroden op de folie op precieze dikte samengeperst. Dit verhoogt de dichtheid en daarom ook de prestaties van de elektroden.
5. Snijden
In deze machine worden de elektroden in het juiste formaat gestanst. Er zijn meerdere methoden om te snijden die afhankelijk zijn van de mate van complexiteit tot productieschaal.
6. Vacuümdrogen
In essentie betekent dit de allerlaatste vochtopname uit het gecreëerde materiaal, zonder daarbij de prestaties van het product te beïnvloeden. Door vacuüm kan men met lagere droogtemperaturen heel goed vocht laten verdampen.
7. Assembleren
De batterijcel wordt geassembleerd door het stapelen (prismatisch) of wikkelen (cilindrisch) van elektroden. Vervolgens worden deze cellen in een behuizing geplaatst.
8. Opvullen
De behuizing wordt ingespoten met de elektrolyt, dat zorgt voor de elektrische geleiding.
9. Verzegeling
De cel wordt afgedicht, zodat de elektroden en het elektrolyt veilig in de behuizing blijven en om lekkage te voorkomen.
10. Formatie en conditionering
In deze fase vinden laad- en ontlaadtesten plaats.
11. Assemblage pakketten en modules
Het samenstellen van meerdere batterijcellen
AAN WELKE EISEN MOET
KLEDING WORDT BIJ WELKE PROCESSTAP GEDRAGEN?
Er zijn geen wettelijke normen voor batterijproductie ten aanzien van cleanroomomgevingen. Het gaat erom dat de batterijproducent zijn eigen eisen per processtap in haar productie duidelijk heeft, zodat de kwaliteit van het eindproduct (batterij) is gewaarborgd.
Het begint met een risk assessment in iedere stap van het proces, waarbij bepaald moet worden in welke gradatie het product beschermd moet worden, of operators ook beschermd moeten zijn of wellicht een combinatie van beide. In dat kader zie je al onderlinge verschillen bij bedrijven of een bepaalde processtap plaatsvindt in een cleanroom of niet.
Om een aantal risico’s te benoemen kun je denken aan ontlading richting compo -
nenten of elektronica, ontlading waaruit brand kan ontstaan, stofdeeltjes of chemische poeders, of chemische vloeistoffen. Dit klinkt wellicht nog wat abstract. Een voorbeeld is het mixen van grondstoffen (slurry). Enerzijds is dit natuurlijk een omgevingsvervuilend proces, zo ook voor de operator, als er geknoeid wordt, want het gaat immers over grafiet en verschillende andere soorten metalen die een gezondheidsrisico kunnen vormen. Dit zou kunnen betekenen dat de operators persoonlijke beschermingsmiddelen moeten dragen en dat dit mogelijkerwijs een werkkledingstuk is welke niet geschikt is voor cleanrooms gezien de mate van deeltjesafgifte. Anderzijds, hoe schoner een grondstof, of wel hoe minder gecontamineerd een grondstof wordt gemaakt, dus in een cleanroomomgeving en met cleanroomkleding aan, des te beter de grondstof ervoor gaat zorgen dat de performance van de batterij optimaal is.
Daarnaast is het ook nog eens afhankelijk of een specifieke processtap plaatsvindt in een gesloten systeem of een open systeem. Stel dat het droogproces plaatsvindt in een totaal afgesloten systeem, waar dit systeem in essentie een mini-cleanroom is, dan kan men dit vergelijken met een isolator, waarbij men buiten de isolator niet volgens een streng kledingregime hoeft te werken. Tenzij er op sommige momenten wellicht een interventie moet plaatsvinden tijdens het proces, waarbij dan wel geldt dat er goede bescherming aanwezig moet zijn. Opnieuw is dan dus het proces bepalend in hoeverre er bescherming aanwezig moet zijn en voor wie of wat dat dan geldt.
ESD
In alle fasen van de productie van autobatterijen moeten kledingstukken antistatische bescherming bieden tegen elektrostatische ontlading (ESD). ESD kan namelijk schade en storingen veroorzaken aan gevoelige elektronische componen-
ten (zoals batterijen), of kan zelfs leiden tot een brandbare ontlading.
Stoffen en kledingstukken zijn ontworpen om te voldoen aan de beschermende vereisten voor de afzonderlijke processen binnen de batterijproductie. Dit varieert van cleanroomkleding voor de beheersing van deeltjes tot vlamvertragende, chemisch bestendige en waterdichte kleding. Elk type kledingstuk stelt verschillende eisen aan de antistatische veiligheidsprestaties.
Voor batterijproductie, waarbij gewerkt wordt volgens de IEC 61340-normering voor antistatische controle in cleanrooms van klasse 6, worden de prestaties van kledingstukken gedefinieerd volgens de testmethoden zoals vastgelegd in de IEC 61340-normering. Deze norm is echter alleen van toepassing wanneer zowel het kledingstuk als de drager volledig geaard zijn, zoals de werkpraktijk van IEC 61340 voorschrijft.
Buiten volledig geaarde cleanroomomstandigheden is de primaire norm voor het definiëren van de antistatische prestaties van werkkleding vastgelegd in EN 1149-5. Deze norm garandeert dat kleding het risico op statische ontlading tot een minimum beperkt. Dit geldt ook voor cleanroomkleding die wordt gedragen in omgevingen waar volledige aarding niet mogelijk is.
Men moet erom denken dat hoe lager de weerstand (bijvoorbeeld 105 Ω), des te sneller de afvloeiing kan gaan en dat een
Afbeelding 3: De energietransitie zorgt voor een exponentiële groei van de batterijproductie.
dergelijk kledingstuk bij verkeerd gebruik zijn eigen ontlading kan veroorzaken [5]
Om een beeld te schetsen hoe snel iets kan gaan en wat het kan veroorzaken: Een niet-geaard persoon, kan eenvoudig een spanning tot wel 20.000 Volt op het lichaam dragen zonder dit direct te merken. Wanneer deze lading plotseling ontlaadt, via de kleding of lichaam, kunnen er ernstige gevolgen optreden. Hieronder enkele voorbeeldwaarden die de impact van elektrostatische ontlading aantonen:

• 2.000 Volt kan al leiden tot een merkbare statische schok;
• 7.000 Volt is voldoende om een ontbranding van een waterstof/luchtmengsel te veroorzaken;
• 12.000 Volt kan een brandbare ontlading veroorzaken bij benzinedampen in lucht.
Kortom, producten met geleidende draden die ontworpen zijn voor gebruik in volledig geaarde situaties, zoals cleanrooms voor elektronica, kunnen erg gevaarlijk zijn wanneer de drager niet volledig geaard is. Om bescherming te garanderen waar volledige aarding niet mogelijk is, wordt bijvoorbeeld Nega-Stat® P190 ingezet, dat speciaal is ontworpen om te werken zonder volledige aarding. Dit heeft ermee te maken dat deze stof kern-geleidende eigenschappen heeft en niet oppervlakte-geleidende eigenschappen. In wezen zit de beschrijving al in de woorden, waarbij de ene de geleidende eigenschappen aan de oppervlakte houdt en daardoor snel kan afvoeren, zit dit bij de andere in de kern van de garens, waardoor het risico verminderend werkt.
Het gaat hier echt over ongeaarde situaties. Kleding met oppervlakte-geleidende garens kan dus zelfs gevaarlijker zijn dan kleding met geen geleidende garens aangezien de ontladingssnelheid juist ver-
hoogd wordt. Bij kern-geleidende garens is dit dusdanig ontworpen dat de statische lading langzaam en gecontroleerd wordt geneutraliseerd. Een voorbeeld hiervan is Nega-Stat® P190 dat een draad/garen is die het elektrische veld van het oppervlak van de stof aantrekt en alle vrije lading op het oppervlak van het materiaal neutraliseert. Als gevolg hiervan kan de oppervlaktelading worden gereduceerd tot nul Volt. Materialen die Nega-Stat® P190 bevatten, hoeven niet perse volledig geaard te zijn om effectief te zijn. Nega-Stat® P190 kan daarom worden gebruikt in een breed scala aan industriële toepassingen waar volledige aarding niet mogelijk of onpraktisch is [6]
Deze paragraaf begon over dat er geen speciale cleanroom normeringen worden gehanteerd binnen de batterij industrie, maar er zijn wel een aantal andere noemenswaardige normeringen [7]:
• UN DOT 38.3 en IEC 62281: verplicht als men internationaal of van/naar/binnen de VS wil verschepen, alle beschreven tests in deze normering moeten met succes worden afrond.
• IEC 62619: deze norm zorgt ervoor dat batterijen zijn ontworpen voor hun toepassing en heeft verschillende faalscenario-tests.
• UL 1642: is een celgerichte test waarbij de cellen een groot aantal tests onder-
KLEDING MET OPPERVLAKTE-
GELEIDENDE GARENS KAN DUS ZELFS
GEVAARLIJKER ZIJN DAN KLEDING
MET GEEN GELEIDENDE GARENS
AANGEZIEN DE ONTLADINGSSNELHEID
JUIST VERHOOGD WORDT.
gaan die aantonen dat ze in staat zijn om met relatief extreme omstandigheden om te gaan.
• UL 2054, UL 2271 en UL 2580: dit zijn normeringen die direct verband houden met een bepaalde toepassing waarvoor de lithium-ionbatterij wordt gebruikt. Respectievelijk houdt dit in dat er een aparte regulatie is voor een kleinere batterij welke gebruikt wordt voor een scheerapparaat. Een aparte regulatie voor een grotere batterij welke voor een elektrische fiets wordt gebruikt en uiteraard nog verder, een elektrische auto.
UITDAGINGEN EN ONTWIKKELINGEN
BATTERIJ INDUSTRIE
Een van de grote uitdagingen in de industrie zijn de grondstoffen die gebruikt worden. Lithium en kobalt zijn schaarse grondstoffen waarvan de winning milieuproblemen en gezondheidsproblemen veroorzaakt. In sommige gevallen gaat de winning van de grondstoffen zelfs ten koste van de mensenrechten.
Daarnaast is het gebruik van metalen zoals koper en nikkel ook schadelijk voor het milieu, omdat deze metalen niet afbreken.
Enerzijds is de winning dus al een duurzaamheidsprobleem en aan de andere kant zouden de metalen in het milieu kunnen komen na het wassen van de kleding.
In veel gevallen is het zelfs een uitdaging om kleding weer vlekvrij te krijgen vanwege de grondstoffen grafiet en andere metalen. Dit zou niet mogen gelden voor cleanroomkleding, aangezien vlekken deeltjes impliceren en dat wil men juist met een cleanroom zien te voorkomen. Ook al zou men deze uitdaging willen omzeilen door gebruik van een wegwerpartikel, dan nog komen de grondstoffen met het wegwerpartikel in het milieu. Dit zijn al bekende constateringen waar aan wordt gewerkt in de vorm van filterplaatsing na het wassen van kleding,
zodat de metalen kunnen worden opgevangen en op de juiste manier worden afgevoerd en hergebruikt. Of in geval van cleanroomkleding, eerst een voorwas buiten de cleanroomwasserij te implementeren, waardoor risico op kruisbesmetting gereduceerd is.
Ook binnen de batterij-industrie zelf zijn ze al op zoek naar een duurzamere oplossing op gebied van grondstoffen. De batterij van de toekomst moet bestaan uit natrium (ons gewone keukenzout: de zeeën zitten er vol mee) [8]
Volgens professor Erik Kelder, associate professor of the Storage of Electrochemical Energy Section at the Faculty of Applied Sciences at Delft University of Technology, is deze technologie bestand tegen hogere temperaturen, milieuvriendelijker, makkelijk te recyclen en presteert beter tegen kou. Ook zou de technologie goedkoper zijn dan batterijen met daarin nikkel, kobalt en mangaan [9]. Dat er onderwijl naarstig wordt gezocht naar nog betere en kostenefficiëntere oplossingen wordt ondersteund in het rapport Sodium-Ion Batteries 2025-2035 [10]
Schoonmaak
Een andere grote uitdaging is gelieerd aan schoonmaak vanwege het gebruik van grafiet. Dit is een zwart fijnstof dat, zelfs zichtbare, contaminatie achterlaat op de kleding en in de werkruimten op oppervlakken. Om die reden is het van
groot belang deze ruimten en kleding ook zo goed mogelijk schoon te maken en te houden. Het gebruik van water is enorm geleidend en om die reden wordt er soms gekozen voor een snel verdampende oplossing, zoals ethanol. Dit is een desinfectans met een enorm hoog explosiegevaar, en dat is niet aan te raden. Een manier om water minder te laten geleiden is gebruikmakend van schuim (denk maar aan de schuimbrandblusser die het vermogen heeft om elektriciteit te blussen). Dit houdt dus in dat er gereinigd moet worden met water met een juist gedoseerde zeepoplossing. Dit zou bijvoorbeeld gevalideerd kunnen worden met een pre-prepared moppensysteem.
De batterij-industrie is een exponentieel groeiende industrie, waar cleanrooms zeker een rol in spelen. Het doel is om de batterij een zo lang mogelijke levensduur te bieden met een uitstekende performance en dat met zo laag mogelijke milieubelasting. Daarnaast zal er in de batterij-industrie goed gekeken worden naar verduurzaming en technologische
ontwikkelingen zoals bijvoorbeeld de natriumbatterij en energieopslagmethodes. In ons dagelijks leven zien we, zoals in de introductie geschreven, al een enorme toename aan batterij-toepassingen en die moet vervuld worden. Er zijn om deze redenen enorm veel uitdagingen binnen deze industrie, maar ook zeker kansen voor de toekomst.
[1] https://evmarketsreports.com/europesbattery-supply-to-ramp-up-by-2030/
[2] https://www.asecos.com/asecos_ Whitepaper_Lithium-ion-batteries_ NL/18/
[3] Rudolf, S. (2013). Aufbau einer Fabrik zur Zellfertigung. In R. Korthauer (Ed.), Korthauer, R. (S. 249-257). Berlin: Springer.
[4] Kaiser, J./Wenzel, V. et al. (2014). Prozessund Produktentwicklung von Elektroden für Li-Ionen-Zellen. Chemie Ingenieur Technik, Nr. 5, Jg. 86, S. 695 - 706
[5] Michael Dyer statement, William Barnet and sons
[6] https://www.barnet.com/products/negastat/p190/
[7] https://liiontamer.com/wp-content/ uploads/Top-11-Lithium-Ion-BatteryRegulations.pdf
[8] www.nos.nl/artikel/2509693natriumbatterij-tu-delft-is-belangrijkestap-in-energietransitie
[9] https://www.change.inc/energie/dezebatterijen-gaan-lithium-ion-vervangenmaar-de-vraag-is-wanneer-41278
[10] https://www.idtechex.com/en/researchreport/sodium-ion-batteries-20252035-technology-players-markets-andforecasts/1082


























Innovatie in de halfgeleiderindustrie ontwikkelt zich in een ongekend tempo.
Chips worden steeds krachtiger en complexer, terwijl de wereldwijde vraag naar hoogwaardige microchips blijft gestaag toenemen. Deze trend wordt aangejaagd door de explosieve groei van opkomende technologieën zoals kunstmatige intelligentie, 5Gconnectiviteit, autonome voertuigen en het Internet of Things (IoT).
Daardoor neemt de druk op fabrikanten toe om chips te leveren die kleiner, sneller en efficiënter zijn dan ooit tevoren.

Nederlandse bedrijven, en in het bijzonder ASML, zijn wereldwijd toonaangevend met hun geavanceerde lithografiesystemen voor de productie van halfgeleiders. Naarmate de industrie steeds verder richting nanometerschaal beweegt, nemen de eisen aan reinheid en precisie in productieomgevingen aanzienlijk toe.
Door: Ronald van Lierop* en Guud Staaltjens**, *Alcochem Hygiene Nederland, **Romex B.V.
Cleanroomtechnologie moet zich aanpassen aan steeds strengere eisen. Elke vorm van verontreiniging, of het nu gaat om deeltjes, chemische resten of biologische contaminanten, kan defecten veroorzaken in halfgeleiderwafers, wat leidt tot prestatieverlies of uitval. Op zulke kleine schaal kan zelfs één stofdeeltje een circuit onbruikbaar maken. Reinheid is daarom niet slechts een aanbeveling, maar een essentiële vereiste.
Fotolithografie, het hart van chipproductie, is bijzonder gevoelig voor contaminatie. In dit proces worden patronen met behulp van ultraviolette straling (meestal DUV of EUV) overgebracht op een siliciumwafer. Deze patronen vormen de functionele structuren van transistoren en andere componenten. Als de optische weg wordt belemmerd door deeltjes of residuen, wordt de patroonvorming verstoord met potentieel desastreuze gevolgen.
REINHEID CLASSIFICATIE
ASML onderkent het kritieke belang van reinheidsbeheer. Om de prestaties en betrouwbaarheid van hun apparatuur te waarborgen, hanteert ASML een streng reinheidsclassificatiesysteem. Hierbij worden componenten, materialen en oppervlakken onderverdeeld in reinheids-

Afbeelding 1: Reinheidsinspectie met UVA-lamp. (Bron Eriks | Lean in Clean).
klassen, waarvan grade 2 en grade 4 het meest gangbaar zijn. Elke klasse definieert de maximale toegestane hoeveelheid deeltjes- en moleculaire verontreiniging gebaseerd op uitgebreide test- en functieanalyses.
Grade 2-componenten bevinden zich dicht bij het optische systeem of de waferstage en vereisen daarom de hoogste graad van reinheid. Deze onderdelen ondergaan intensieve reinigingsprocedu-
CHIPPRODUCTIE, IS BIJZONDER GEVOELIG VOOR CONTAMINATIE.
res, bestaan uit cleanroomcompatibele materialen en worden onderworpen aan strikte visuele inspecties. Grade 4-componenten bevinden zich in minder kritieke zones en mogen aan iets ruimere toleranties voldoen.
Het bereiken en behouden van deze reinheidsgraden vergt een uitgebreide samenwerking in de gehele toeleveringsketen. Leveranciers moeten werken in gecontroleerde omgevingen, gebruikmaken van gecertificeerde materialen en strategieën toepassen om contaminatie te minimaliseren. Reiniging gebeurt onder meer met ultrapure oplosmiddelen, ultrasone baden en vacuüm bake-out procedures. De onderdelen worden vervolgens verpakt in voor cleanroomgeschikte verpakkingen en onder gecontroleerde omstandigheden getransporteerd.
De verificatie van de reinheid is van even groot belang. ASML en haar toeleveranciers gebruiken diverse analysemethoden om de aanwezigheid van deeltjes of moleculaire verontreiniging te meten, zoals oppervlaktedeeltjestellers, gaschromatografie (GC-MS) en uitgassingstests onder vacuüm. Echter, een van de meest praktische en veelgebruikte technieken is visuele inspectie met behulp van UV-A inspectielampen.
Een hoogwaardige UV-A inspectielamp zendt ultraviolet licht uit met een golflengte tussen 320 en 400 nm. Dit type licht laat veel organische en anorganische verontreinigingen fluoresceren. Reststoffen zoals koolwaterstoffen, siliconenoliën en fotolakresten worden onder UV-A belichting zichtbaar en lichten vaak fel op tegen de verder schone achtergrond. Daardoor kunnen vervuilingen worden waargenomen die met het blote oog onder normaal licht onzichtbaar blijven.
UV-A inspectie is bijzonder effectief op kritische oppervlakken zoals waferstages, optische vensters en gereedschappen in cleanrooms. Omdat deze methode direct en niet-destructief is, leent zij zich uitstekend voor snelle kwaliteitscontroles tijdens assemblage, verpakking en onderhoud. Moderne UV-A lampen zijn bovendien draagbaar, waardoor ze ook bruikbaar in gesloten systemen zoals glove boxes of bij veldinspecties.
Y = Afstand (mm)
Intensiteitsgraf iek UV-A Licht (365 nm)
Afstand lamp = 30 cm
2:
Ondanks de gebruiksvriendelijkheid zijn er bij UV-A inspectie belangrijke technische randvoorwaarden. De lichtintensiteit, spectrale zuiverheid, de kijkhoek, omgevingslicht en de ervaring van de operator beïnvloeden de gevoeligheid van de detectie. Om consistentie te waarborgen stellen veel bedrijven gestandaardiseerde inspectieprotocollen op en verzorgen zij gerichte trainingen voor cleanroompersoneel.
X = Intensiteit (mW/cm2)
Het groeiende gebruik van UV-A inspectielampen weerspiegelt een bredere beweging richting proactief reinheidsbeheer in de halfgeleiderindustrie. Door contaminatie vroegtijdig te detecteren, kunnen fabrikanten defecten in latere productiestadia voorkomen, verspilling reduceren en de yield verhogen. Dit sluit aan bij industriestandaards voor continue verbetering, zoals Six Sigma en lean manufacturing.
Daarnaast groeit de inzet van UV-A inspectie buiten traditionele kwaliteitscontrole. In R&D-omgevingen wordt deze technologie gebruikt voor het testen van reinigingsmethoden, materiaalcompatibiliteit en faalanalyse. In een regulatoire context ondersteunt UV-A inspectie de naleving van normen zoals ISO 14644-1 (cleanroom classificatie) en SEMI-richtlijnen voor contaminatiebeheersing.
Om een betrouwbare detectie van contaminatie mogelijk te maken, moet een UV-A inspectielamp aan een aantal belangrijke technische en functionele specificaties voldoen. Hieronder worden de tien meest essentiële kenmerken opgesomd waaraan een professionele UV-inspectielamp voor cleanroom gebruik moet voldoen:
Door het naleven van deze specificaties kan de effectiviteit van UV-A inspectie worden. Deze lampen dragen bij aan een betrouwbare kwaliteitsborging binnen de streng gereguleerde omgeving van cleanroomproductie.
Kortom, reinheid is niet langer een randvoorwaarde in de productie van halfgeleiders, maar vormt een kernvoorwaarde voor functionele prestaties. De reinheidsclassificaties van ASML illustreren de mate van nauwkeurigheid die nodig is om foutloze lithografiesystemen te leveren. UV-A inspectielampen zijn hierin een onmisbaar hulpmiddel gebleken. Naarmate de industrie zich verder ontwikkelt, zal de inzet van geavanceerde inspectietechnologieën, zoals UV-A belichting in cleanroomomgevingen essentieel blijven voor innovatie, betrouwbaarheid en productie-efficiëntie.
1 Ergonomie & Veiligheid
2 Lichtbron
3 Materiaal & Afwerking
4 Dubbele lichtopbrengst
5 Lichtintensiteit (wit)
6 UV-lichtintensiteit
7 Constante output
8 Interferentiefilter
9 Warmteregeling
10 Voeding & Opladen
De lamp moet handzaam, niet te zwaar en compact zijn voor langdurig gebruik. Bovendien moet ze voldoen aan de geldende veiligheidsnormen en bestand zijn tegen stoten en vallen.
Moderne UV-LED’s hebben de voorkeur boven fluorescentielampen vanwege hun energiezuinigheid, snelle opstarttijd en lange levensduur.
De behuizing dient glad, niet-poreus en goed reinigbaar te zijn. Hoogwaardige aluminiumlegeringen (zoals T6061 Type III) bieden extra duurzaamheid en contaminatiebestendigheid.
Voor een volledige inspectie moet de lamp zowel UV- als wit licht kunnen uitstralen, bij voorkeur schakelbaar via een eenvoudige interface.
Een goed afgestelde witte LED moet minimaal 300 lumen op 30 cm afstand leveren om voldoende strooilicht te geven.
Een minimale UV-intensiteit van 10 mW/cm² op 30 cm afstand bij een golflengte van 365 nm (±5 nm) is vereist voor effectieve visualisatie van kleine contaminanten.
De lichtoutput dient stabiel te blijven tijdens het gebruik. Goede lampen schakelen pas uit bij een lege batterij, zonder geleidelijke afname van intensiteit.
Een geïntegreerd interferentiefilter zorgt voor comfort en visuele scherpte door alleen het relevante UV-spectrum door te laten, met minder dan 50 lux aan zichtbaar restlicht.
Efficiënte warmtedissipatie voorkomt oververhitting en waarborgt een stabiele golflengte en lange levensduur van de LED’s
De lamp moet gebruikmaken van krachtige en veilige Li-ionbatterijen (zoals bijvoorbeeld van Panasonic/Sanyo), met bescherming tegen overladen. Inductief laden is ideaal om stofinsluiting, bij het openen van de behuizing tijdens het vervangen van de batterij te vermijden.







Ons gezichtsveld kan worden onderverdeeld in een centraal en perifeer gedeelte.
Bij het gebruik van veiligheidsbrillen of andere persoonlijke beschermingsmiddelen (PBM) voor het gezicht en meer specifiek rond de ogen zal dit veelal ons gezichtsveld, ook wel “Field of View” of FoV genoemd, verkleinen. Een kleinere FoV kan, via een vermindering van onze visuele capaciteiten, een negatief effect hebben op handelingen die moeten worden uitgevoerd. Vandaar dat het FoV, die kan verschillen tussen diverse veiligheidsbrillen, een rol moet spelen in de uiteindelijke keuze, rekening houdend met de uit te voeren taken.




Hoewel het belang van een veilige werkomgeving wordt erkend, vereist de naleving van de PBM-regels en -richtlijnen voortdurende aandacht en inspanningen van alle belanghebbenden. Voor oogletsels in het bijzonder blijkt dat veel van deze letsels het gevolg zijn van risicovolle beroepsactiviteiten gerelateerd aan landbouw, bouw en productie (Kyriakaki et al. 2021). PBM’s zijn echter ook van cruciaal belang voor werknemers in gecontroleerde omgevingen. De vraag naar en het gebruik van PBM’s is sinds het begin van de COVID-19-pandemie significant toe-
Een veilige en gezonde werkomgeving is een aandachtspunt voor zowel de industrie als overheidsinstanties. Een van de instrumenten hiervoor is de bevordering van het gebruik van persoonlijke beschermingsmiddelen (PBM). Dit vereist dat fabrikanten van PBM’s producten ontwikkelen die adequate bescherming bieden, maar bovendien rekening houden met ergonomie en comfort. In dit artikel wordt het effect van een verminderde ‘field of view’ bij het gebruik van veiligheidsbrillen besproken.
Door: Hugo Corstjens, Consulent in health & beauty founder of Novigo+ en Stefaan Vanhalle, R&D Manager STAXS®
genomen in ziekenhuizen, als een manier om de overdracht en verspreiding van het virus te voorkomen.
Daarnaast worden PBM’s gebruikt in laboratoria in verschillende disciplines, waar PBM’s de drager en collega’s beschermen tegen mechanische risico’s, blootstelling aan straling en de schadelijke effecten van chemicaliën. Een bijkomende functie van PBM’s is te vinden in cleanrooms, waar het vermijden van verontreinigingen van de te vervaardigen producten cruciaal is. Het aantal chemische letsels op het werk is vrij laag (Lurati, 2015), maar ze kunnen ernstig zijn en een onmiddellijk ingrijpen vereisen. Talrijke ongevallen gebeuren door het ontbreken of onjuist gebruik van PBM’s. Oogletsel is geen uitzondering en naar schatting kan 90% van de oogongevallen worden voorkomen door het gebruik van de juiste persoonlijke beschermingsmiddelen (Kaiti et al., 2020).
PBM’S HEBBEN INVLOED OP HET FYSIEKE EN MENTALE
WELZIJN EN DE PRESTATIES
Ondanks het onbetwistbare belang van oogbescherming, zijn er verschillende redenen waarom werknemers deze negeren. Recente studies van eerstelijnszorgverleners tijdens de COVID-19-crisis werpen enig licht op de naleving van het gebruik van PBM’s. Vaak gemelde PBMgerelateerde ongemakken zijn hoofdpijn
(79% van de respondenten), huiddrukletsel (66%), duizeligheid (49%), slecht zicht (27%) en vermoeidheid (16%) (Duan et al., 2020; Xiao-huan et al., 2020; Swaminathan et al., 2020). Bovendien rapporteren deze studies nadelige effecten op het welzijn, zoals een algemene toename van mentale stress, angst (12%), slapeloosheid (7%) en depressie (6%). Het is dan ook geen verrassing dat deze symptomen een negatieve invloed hebben op werkgerelateerde prestaties en productiviteit. Volgens de deelnemers aan de studie is dit onder meer te wijten aan beperkingen in vaardigheden en verminderd gezichtsvermogen.
De studie van Xiao-Huan et al. (2020) is van bijzonder belang omdat het specifiek de effecten van een veiligheidsbril op de gezondheid en arbeidsomstandigheden van verpleegkundigen onderzoekt tijdens het omgaan met de COVID-19 pandemie. Ongeveer 10% van de deelnemers geeft aan dat ze als gevolg van het dragen van een veiligheidsbril in onveilige situaties zijn terechtgekomen waarin virale infectie of overdracht mogelijk was. Bovendien meldt ongeveer 20% van de respondenten dat ze een medische fout hebben gemaakt, gedefinieerd als een mislukte klinische procedure zoals mislukte bloedafname of medicatiefouten, die in verband kan worden gebracht met bril-gerelateerde ongemakken. Ondanks
de onbetwistbare voordelen van een veiligheidsbril op het gebied van oogbescherming, geven deze onderzoeken aan dat deze werkomstandigheden onveilige situaties kunnen creëren voor zowel verpleegkundigen als patiënten. Alhoewel er weinig cijfers beschikbaar zijn over de effecten van veiligheidsbrillen in andere gecontroleerde omgevingen, zoals in cleanrooms en laboratoria, kan er worden aangenomen dat dergelijke problemen ook hier optreden. Het is van primair belang om veiligheidsbrillen te ontwerpen die voldoen aan de behoeften van de gebruikers, zodat alle barrières die de bredere acceptatie van deze PBM’s in de weg staan, worden weggenomen.
‘FIELD OF VIEW’ (FOV)
Eerder is gemeld dat condensatievorming en het ontstaan van krassen twee belangrijke obstakels zijn voor het gebruik van veiligheidsbrillen (Lombardi et al., 2009). Oplossingen in de vorm van anticondensatiecoatings en behandelingen en designs met verbeterde ventilatie capaciteiten enerzijds en harde coatings met specifieke materiaalkeuzes en dui-
delijke richtlijnen voor reiniging anderzijds zijn hiervoor reeds ontwikkeld. In dit artikel willen we een ander kenmerk van een bril bespreken, namelijk het ‘field of view’ (FoV). Het FoV of het gezichtsveld is de breedte van het gebied dat de ogen van een persoon kunnen zien wanneer ze op een centraal punt zijn gericht. Voor gezonde mensen is dit ongeveer 200° tot 220° in een horizontaal vlak, zoals geïllustreerd in figuur 1. De term FoV wordt gebruikt met betrekking tot de beperking van wat kan worden gezien door externe toestellen of systemen, zoals het dragen van een (sport)bril, VR-headset of veiligheidsbril. Het meest geschikte gezichtsveld hangt af van de taak die moet

Afbeelding 1: Het gebruik van PBM, waaronder veiligheidsbrillen, is in sommige gevallen verplicht of wordt aangeraden.
worden uitgevoerd. Het gezichtsveld van een verrekijker varieert afhankelijk van de vergroting, maar ligt meestal rond de 7°. Voor VR-headsets ligt een typische FoV rond de 50° (Lynn et al., 2020). De minimale FoV-vereisten voor sportbrillen zijn afhankelijk van de discipline. Voor een overzicht zie Dain (2016).
Ons begrip van de verdeling van visuele aandacht tijdens het plannen van interactie met objecten, zowel binnen als buiten het gezichtsveld, is een complex gegeven (Lavoie et al. 2018) en valt buiten het bestek van dit artikel. Het moet wel worden opgemerkt dat volgens de « two-stream-hypothesis » (Goodale 2011) er een anatomisch en functioneel verschil is tussen visuele informatie die verloopt via de ventrale en dorsale stroom. Het ventrale pad, gekenmerkt door een hoge resolutie en object-identificatie, wordt ook wel “vision-for-perception” genoemd. Het dorsale pad resulteert in minder details en is meer gericht op ruimtelijke locatie en beweging en wordt daarom “vision-for-action” genoemd. Volgens deze hypothese worden beide paden met respectievelijk het foveale (centrale deel van ons gezichtsvermogen met de hoogste gezichtsscherpte) en perifere zicht (waarnemen van beweging en het krijgen van een algemeen overzicht) geassocieerd. De rol van het perifere zicht in dagelijkse taken, zoals wandelen en autorijden, wordt besproken in een review van Vater et al. (2022). Het bestaan van beide paden
(https://commons.wikimedia.org/wiki/File:Peripheral_vision.svg)
impliceert dat een beperking van het FoV verder gaat dan een eenvoudige verkleining van het gezichtsveld maar bovendien een potentiële impact heeft op specifieke functies van ons gezichtsvermogen.
Uit bovenstaande kan worden afgeleid dat perifere slechtziendheid de fysieke prestaties beïnvloedt. Omgekeerd kan een efficiënt perifeer gezichtsveld bijdragen aan de prestaties in verschillende sporten waaronder de meeste balsporten, skiën, autoracen, etc. Het is bijvoorbeeld gerapporteerd dat fast-pitch softbalspelers een groter gezichtsveld hebben in vergelijking met een controlegroep van niet-atleten (Berg & Killian, 1995). Uit een studie van Kauffman et al. (2014) bleek dat een sportbril de perceptie van een visuele prikkel in het perifere gezichtsveld nadelig beïnvloedt. Uit hetzelfde onderzoek werd geconcludeerd dat een veiligheidsbril de verwachte prestatieverbeteringen bij herhaling van het experiment in de weg staat. Ook in het dagelijks leven is aangetoond dat een beperking van het
gezichtsveld het gedrag van mensen beïnvloedt en de prestaties vermindert. Arthur (2000) onderzocht het effect van beperkt gezichtsveld op twee eenvoudige taken, namelijk het zoeken naar een doelwit en het lopen door een doolhofachtige omgeving. Een vermindering van
het gezichtsveld van 176° naar 112° had een negatieve invloed op de taakprestaties, gemeten als een toename van de zoektijd en looptijd met respectievelijk 13,5% en 30,6%. Toet et al. (2008) rapporteerde vergelijkbare resultaten, maar deze auteurs gebruikten een niet-gelimiteerd blikveld, met een FoV van ongeveer 200°, als referentie. De tijd om een looptest af te ronden met een verminderd gezichtsveld tot 120° neemt met 23% toe in vergelijking met de onbeperkte controle. Ook het aantal voetstappen neemt met 22% toe. Deze auteurs veronderstellen dat de beperking van het gezichtsveld leidt tot een verslechtering van het evenwicht en een daarmee gepaard gaande afname van het zelfvertrouwen.
In een andere studie werd het effect van een FoV-restrictie op het visuele scanningsgedrag gemeten tijdens het uitvoeren van verschillende mobiliteitsactiviteiten zoals wandelen, fietsen en een straat oversteken. (Postuma et al. 2025) Een FoV restrictie tot 90° associeerde met het maken van meer horizontale hoofd-

Afbeelding 2: Het gebruik van een veiligheidsbril heeft een significant effect op de visuele prestaties waaronder de FoV.
bewegingen met grotere amplitudes, en een vermindering van de horizontale oogpositie naar de perifere gebieden. Dit suggereert een compensatiemechanisme door meer en vooral grotere hoofdbewegingen te maken, maar het verkrijgen van de nodige visuele informatie kan onder deze omstandigheden nog steeds een uitdaging zijn.
Uit bovenstaande studies kan worden geconcludeerd dat een beperkt gezichtsveld een negatieve invloed heeft op het vermogen om te manoeuvreren en op de taakuitvoering in uiteenlopende omgevingen en omstandigheden. Het is aannemelijk dat dergelijke beperkingen zich ook voordoen tijdens beroepsactiviteiten in gecontroleerde omgevingen, waaronder laboratoria en cleanrooms. Om de veiligheid op de werkplek te garanderen, het risico op fouten tijdens de uitvoering van de taak te minimaliseren en het comfort tijdens de taakuitvoering te vrijwaren, wordt het verstrekken van geschikte veiligheidsbrillen ten zeerste aanbevolen. Een FoV, aangepast aan de taak die moet worden uitgevoerd, is hierbij een factor die men het best niet over het hoofd ziet.
Het naleven van het gebruik van veiligheidsbrillen in gecontroleerde en risicovolle omgevingen, moet worden gestimuleerd en ondersteund. Op basis van wetenschappelijke studies kan worden geconcludeerd dat een beperking van het FoV een significant effect heeft op de visuele prestaties van personen en hierdoor bepaalde handelingen negatief kan beïnvloeden. Met betrekking tot personen actief in laboratoria en cleanrooms stellen we dat het gezichtsveld van veiligheidsbrillen een relevante factor is, waarbij een breder gezichtsveld bijdraagt aan het comfort, de veiligheid en de kwaliteit van de taakuitvoering voor de gebruiker. De FoV van dergelijke brillen moet bijgevolg mee worden gewogen in
het besluit vormingsproces bij het selecteren en aanschaffen van deze persoonlijke beschermingsmiddelen. Voor meer interessante artikelen bezoek zeker de webste www.STAXS.eu, ga naar www.cwscleanrooms. com of scan de QR code.
[1] Arthur, K. (2000). Effects of Field of View on Performance with Head-Mounted Displays (Doctoral dissertation, University of North Carolina at Chapel Hill, Department of Computer Science.
[2] Berg WP, Killian SM. Size of the visual field in collegiate fast-pitch softball players and nonathletes. Percept Mot Skills. 1995 Dec;81(3 Pt 2):1307-12. doi: 10.2466/ pms.1995.81.3f.1307.
[3] Dain SJ. Sports eyewear protective standards. Clin Exp Optom. 2016 Jan;99(1):4-23. doi: 10.1111/cxo.12349.
[4] Duan X, Sun H, He Y, Yang J, Li X, Taparia K, Zheng B. Personal Protective Equipment in COVID-19: Impacts on Health Performance, Work-Related Injuries, and Measures for Prevention. J Occup Environ Med. 2021 Mar 1;63(3):221225. doi: 10.1097/JOM.0000000000002123.
[5] Goodale MA. Transforming vision into action. Vision Res. 2011 Jul 1;51(13):156787. doi: 10.1016/j.visres.2010.07.027.
[6] Kaiti Raju, Shyangbo Ranjila, Paudel Bhawana, Mishra Ankita. Personal Protective Equipment for Occupational Safety and Ocular Health -A Review. EC Ophthalmology . 2020 11.7 61-66.
[7] Kauffman DC, Clark JF, Smith JC. The influence of sport goggles on visual target detection in female intercollegiate athletes. J Sports Sci. 2015;33(11):1117-23. doi: 10.1080/02640414.2014.987156.
[8] Kyriakaki ED, Symvoulakis EK, Chlouverakis G, Detorakis ET. Causes, occupational risk and socio-economic determinants of eye injuries: a literature review. Med Pharm Rep. 2021 Apr;94(2):131-144. doi: 10.15386/ mpr-1761.
[9] Lavoie EB, Valevicius AM, Boser QA, Kovic O, Vette AH, Pilarski PM, Hebert JS, Chapman CS. Using synchronized eye and motion tracking to determine highprecision eye-movement patterns during object-interaction tasks. J Vis. 2018 Jun 1;18(6):18. doi: 10.1167/18.6.18.
[10] Lombardi DA, Verma SK, Brennan MJ, Perry MJ. Factors influencing worker use of personal protective eyewear. Accid Anal Prev. 2009 Jul;41(4):755-62. doi: 10.1016/j.aap.2009.03.017.
[11] Lurati A. Occupational-Related Chemical Injuries: A Review of the Literature. Workplace Health Saf. 2015 Jul;63(7):284-7. doi: 10.1177/2165079915576924.
[12] Lynn MH, Luo G, Tomasi M, Pundlik S, E Houston K. Measuring Virtual Reality Headset Resolution and Field of View: Implications for Vision Care Applications. Optom Vis Sci. 2020 Aug;97(8):573-582. doi: 10.1097/OPX.0000000000001541.
[13] Postuma EMJL, Cornelissen FW, Pahlevan M, Heutink J, de Haan GA. Reduced field of view alters scanning behaviour. Virtual Real. 2025;29(2):55. Doi: 10.1007/s10055025-01125-0.
[14] Swaminathan R, Mukundadura BP, Prasad S. Impact of enhanced personal protective equipment on the physical and mental well-being of healthcare workers during COVID-19. Postgrad Med J. 2022 Mar;98(1157):231-233. doi: 10.1136/ postgradmedj-2020-139150.
[15] Toet A, Jansen SE, Delleman NJ. Effects of field-of-view restriction on manoeuvring in a 3-D environment. Ergonomics. 2008 Mar;51(3):385-94. doi: 10.1080/00140130701628329.
[16] Vater C, Wolfe B, Rosenholtz R. Peripheral vision in real-world tasks: A systematic review. Psychon Bull Rev. 2022 Oct;29(5):1531-1557. doi: 10.3758/s13423022-02117-w.
[17] Xiao-huan, H., Yan-ru, F., Gao-ming, L., Xiao-jiao, P., Ting, C., & Ya-li, Z. et al. (2020). The impact of goggle-associated harms to health and working status of nurses during management of COVID-19. https:// doi.org/10.1101/2020.05.11.20094854








§Real-time monitoring van ruimtedruk Alarmfuncties bij afwijkingen voor directe actie
§ Intuïtief touchscreen en overzichtelijke interface
§ Koppeling met gebouwbeheersystemen (GBS)



Het CPS6000 drukbewakingssysteem is dé oplossing voor nauwkeurige en continue bewaking van over- en onderdruk in ruimtes waar luchtkwaliteit en veiligheid essentieel zijn, zoals cleanrooms, operatiekamers en laboratoria.


§ Zekerheid in druk. Betrouwbaarheid in elke situatie. Kies voor het CPS6000 systeem





Full service provider for controlled enviroments
IN CLEANROOM
Al 20 jaar de kracht van ProCleanroom
Vanuit onze expertise is ProCleanroom jouw full service partner voor gecontroleerde omgevingen.
Van ontwerp, fabricage, installatie en ISO-validatie tot het inrichten van de ruimtes, producten en accessoires. Onze oplossingen sluiten naadloos aan op jouw behoeften.
Cleanrooms & Flowkasten
Service & Onderhoud
Cleanroom validaties
Inrichting & Verbruiksartikelen


VCCN heeft in nauwe samenwerking met MOSAiQ een innovatieve training ontwikkeld, waarbij deelnemers leren hun taken in de cleanroom op de juiste manier en met de juiste snelheid uit te voeren. Beweging is namelijk
een van de grote invloedsfactoren van contaminatie in een cleanroom. Deze training is een waardevolle aanvulling op de Cleanroom Gedrag Cursus voor
cleanroommedewerkers van bedrijven die op geregistreerde wijze willen aantonen dat zij getraind zijn in dit onderdeel van contaminatiebeheersing.
VCCN heeft zich als vereniging ten doel gesteld kennis te delen op het terrein van Contamination Control. Een van de middelen is het verzorgen van trainingen, waarbij met name de Cleanroom Gedrag Cursus een belangrijke cursus is voor alle personen die vanuit hun functie een cleanroom moeten betreden.
Een cleanroom is een omgeving die bedoeld is om een schoon product te maken of een schoon proces te laten plaatsvinden. Mensen, apparatuur, grondstoffen en verpakkingen genereren deeltjes (bijvoorbeeld door slijtage) en vormen zo risicofactoren voor contaminatie. Personen zijn vaak de grootste bron van deeltjes. Deze deeltjes worden door mensen, voorwerpen en de lucht getransporteerd. Door beweging zal de lucht gaan wervelen, waardoor neergeslagen deeltjes zullen opwervelen en mogelijk op het product terechtkomen.
Kortom, personen en hun beweging vormen een grote factor voor het contaminatierisico. Met de VCCN Cleanroom Gedrag Cursus worden alle aspecten behandeld die in relatie tot contaminatie een rol spelen bij het werken in een cleanroom, zoals kleding en de invloed van beweging.
De emmissie van deeltjes door personen kan met behulp van voorschriften en geschikte kleding zo laag mogelijk gehouden worden. Daarnaast moeten personen in de cleanroom zorgvuldig bewegen en
zich ervan bewust zijn dat zelfs bijna geen beweging, bijvoorbeeld het houden van een arm boven een product, een risico voor dat product kan vormen (zie afbeelding 1).
Er is nu een speciale training, als aanvulling op de Cleanroom Gedrag Cursus, waarbij personen op innovatieve wijze leren hoe zij zich moeten bewegen tijdens hun werkzaamheden. Denk bijvoorbeeld aan het schoonmaken van een werkbank of cleanroomwanden. De bewustwording richt zich zowel op de bewegingsrichting als de snelheid van bewegen.
VCCN werkt hiervoor samen met MOSAiQ en biedt deze training van een halve dag aan zowel als reguliere opleiding als incompanyopleiding.
Om personen werkzaam in een cleanroom bewust te maken van hun invloed op de luchtkwaliteit en hun bewegingsgedrag, is de Cleanroom Beweeg Training ontwikkeld. Tijdens deze innovatieve training leren personen, met behulp van een geavanceerd bewegingsregistratie-

Afbeelding 1: Een kleine beweging kan al gevaar voor contaminatie opleveren.
systeem, hoe hun bewegingen bijdragen aan de luchtkwaliteit in de cleanroom. Met dit systeem wordt real-time feedback over de bewegingssnelheden gegenereerd, en wordt ervaren welk gedrag gewenst is en hoe dit in de praktijk kan worden toegepast. Na het volgen van deze training beschik je over de praktische vaardigheden om te voldoen aan de richtlijnen voor bewegen in een cleanroom.
Tijdens deze praktijkgerichte training worden de volgende onderwerpen behandeld:
• Het belang van bewegingssnelheden: Inzicht in hoe beweging in de cleanroom de reinheid van de lucht beïnvloedt.
• Real-time feedback op bewegingssnelheden: Gebruik van geavanceerde motion-capturing hardware en software om de snelheid van je bewegingen
te meten en te analyseren tijdens het uitvoeren van standaard handelingen in de cleanroom.
• Simulaties en praktijkervaring:
Je leert en oefent met behulp van een systeem dat je bewegingen registreert en analyseert via sensoren. Je ziet direct hoe je eigen bewegingssnelheden zich verhouden tot de gewenste normen tijdens het uitvoeren van standaard handelingen in de cleanroom.
• Test en Certificaat:
Aan het eind van de training wordt een gestandaardiseerde test afgenomen.
Als je voldoet aan de vastgestelde normen, wordt de training succesvol afgerond en ontvang je een certificaat van succesvolle deelname. Dit certificaat bevestigt jouw vaardigheden in het correct bewegen binnen een cleanroom.
De Cleanroom Beweeg Training is innovatief door het gebruik van de motion capture-oplossing en trainingssoftware van MOSAiQ. Tijdens de training draagt de deelnemer het innovatieve motioncapturing systeem, waarmee zijn of haar bewegingssnelheden nauwkeurig worden gemeten. In combinatie met specifieke trainingssoftware biedt dit een op maat gemaakte training voor cleanrooms.
Deze training is bedoeld voor iedereen die werkt of gaat werken in een cleanroom en inzicht wil krijgen in het juiste gedrag, met specifieke focus op bewegingsgedrag in relatie tot contaminatiereductie.
Duur: Halve dag
Locatie: VCCN, Woerden of incompany
Kosten: Leden: € 950 excl. 21% BTW
Niet-leden: € 1.150 excl. 21% BTW


Afbeelding 2: De Motion capture-oplossing van MOSAiQ voorziet in bewegingssensoren waarmee real-time feedback van de beweging wordt verkregen.

Afbeelding 3: Speciale software zorgt voor real-time feedback van de beweging van de deelnemer.
MOSAiQ biedt een schaalbare oplossing voor het gebruik van motion tracking in verschillende toepassingen. Naast sport- en automotive toepassingen dus ook voor cleanroomomgevingen. Door bewegingsdata te verwerken wordt een objectieve bron geboden voor veiligheid bij de productie van farmaceutische producten, voedingsmiddelen of elektronica.












PBSC MD-Hi
Desinfectie hatch met geïntegreerde
Bioquell waterstofperoxide generator


Bioquell ProteQ
Waterstofperoxide generator voor desinfectie van laboratoria en cleanrooms
Tecnilab-BMI levert reeds meer dan 20 jaar producten en diensten op het gebied van desinfectie oplossingen in de vorm van ruimte desinfectie en/of apparatuur desinfectie. Ook benieuwd wat Tecnilab-BMI voor u kan betekenen? Kijk dan op www.tecnilab-bmi.nl
TI24003 - Tecnilab-BMI - Advertentie CCM - 184x124.indd 1









PBSC MD-Ci
Desinfectie kamer met geïntegreerde Bioquell waterstofperoxide generator


Bioquell L-4
Waterstofperoxide generator voor desinfectie van equipment en ruimten
Vind o.a. Bioquell en PBSC producten exclusief bij Tecnilab-BMI. We help you move forward. www.tecnilab-bmi.nl
Wil jij jouw bedrijf onder de aandacht brengen bij professionals in cleanroomtechnologie en contamination control? Adverteer dan in het vakblad van VCCN.
Waarom adverteren?






• Contamination Control magazine is een belangrijk vakblad in onze branche.



• Een advertentie in het magazine genereert of bestendigt naamsbekendheid bij precies de juiste doelgroep.




• Het magazine wordt vanwege de betrouwbare en onafhankelijke vakinformatie veel gelezen en kent een hoge meeleesfactor.


Contamination Control Magazine verschijnt elk kwartaal en wordt breed gelezen door vakgenoten. Wil je zichtbaar zijn in het volgende nummer? Bekijk de mogelijk heden op onze website.



STARTDATUM 7 OKTOBER

Het belang van een schoon eindproduct en proces neemt in steeds meer sectoren toe. Het gaat om klein, kleiner, kleinst en schoon, schoner, schoonst. In de halfgeleider, life science, high tech productie en foodproductie industrie worden de reinheidseisen steeds strenger. Ben jij als ontwerper, installateur/bouwer, beheerder of Contamination Control engineer betrokken bij comtainatiebeheersing? Dan is een strategische aanpak om reinheidseisen te kunnen vaststellen én te vertalen naar de juiste maatregel noodzakelijk. Ook is brede diepgaande kennis van contamination control en cleanliness onontbeerlijk.



cleanliness in een schone productieketen. De deelnemer is werkzaam bij een adviseur, installateur, leverancier of bij een bedrijf met een cleanroom of schone productieketen.
Na afronding van de opleiding kun je:
• bepalen welke contaminanten producten en processen beïnvloeden;
• vaststellen welke maatregelen nodig zijn voor een controlled environment;
• vragen van interne en externe opdrachtgevers analyseren en behoeften achterhalen;
• reinheidseisen vastleggen in een Programma van Eisen;
• risico-analyse;
• reiniging en desinfectie op productniveau;
• de controlled environment;
• product cleanliness;
• cleanroomontwerp, constructie en beheer;
• HVAC en containment;
• Cleanroomvalidatie en classificatie;
• Specifieke toepassingen;
De opleiding omvat 15 lesdagen en combineert praktijkgerichte bijeenkomsten met zelfstudie, zodat je de opgedane kennis direct kunt toepassen. Na afloop rond je de opleiding af met een erkend post-hbo certificaat van Stichting PHBO.
De nieuwe post-hbo opleiding Contamination Control & Cleanliness van VCCN biedt diepgaande en integrale kennis, gecombineerd met de praktische vaardigheden die ontwerpers, installateurs/ bouwers en beheerders nodig hebben binnen cleanroomtechnologie en schone productieketens. De opleiding is bedoeld voor instromers en reeds ervaren functionarissen werkzaam binnen Contamination Control en cleanliness.
Deze post-hbo opleiding is bedoeld voor hbo’ers en ervaren mbo’ers die werken met contamination control en product
• deze eisen vertalen naar concrete maatregelen voor de realisatie en het gebruik van een gecontroleerde omgeving;
• een strategische aanpak toepassen voor Contamination Control, van analyse tot toepassing, binnen verschillende sectoren als micro/nano, space, life science, health en food.
Tijdens de opleiding verdiep je in onder andere:
• product- en procesanalyse;
• vertalen van reinheidseisen naar maatregelen;
De lessen worden verzorgd door ervaren VCCN-leden uit het werkveld, waaronder:
Philip van Beek, Frans Saurwalt, Koos Agricola, Petra Van Hauwe, Paul Joosten, Bernard Melchers, Aydin Köyük, André van Tongeren en Hans Cools.
Bekijk alle beschikbare cursusdata en andere informatie op www.vccn.nl

Innovatiemanager bij Asito
In mijn rol als innovatiemanager onderzoek ik welke uitdagingen er spelen binnen onze organisatie en bij onze opdrachtgevers. Deze vertaal ik naar concrete en toekomstgerichte oplossingen. De vraagstukken lopen uiteen van operationele uitdagingen tot het inspelen op trends en veranderende klantbehoeften, zoals duurzame inzetbaarheid, verduurzaming en technologische ontwikkelingen. Geen dag daarbij is hetzelfde. De ene dag werk ik geconcentreerd aan nieuwe ideeën, concepten en oplossingen, terwijl ik de andere dag juist midden in de operatie sta om ideeën uit de praktijk te testen. Juist de samenwerking met collega’s van de werkvloer tot aan het management maakt mij werk veelzijdig en inspirerend.
Ik ben geen specialist op één vakgebied, maar mijn kracht ligt in het proces van innoveren, onderzoeken, testen en implementeren. Voor mijn functie is het essentieel om goed op de hoogte te zijn van wat er speelt, zowel binnen als buiten de organisatie: waar lopen onze medewerkers in de praktijk tegenaan, wat verwachten klanten van ons en welke richting willen zij op? Die kennis vind je niet online, maar alleen door aanwezig te zijn op de werkvloer en bij onze klanten.
Wat mij het meeste voldoening geeft, is dat ik met innovaties kan bijdragen aan het verbeteren van de werkomstandigheden van onze medewerkers. Zo hebben we onze dienstverlening rondom cleanrooms verder geoptimaliseerd door processen te vereenvoudigen, kennis te bundelen en praktische handvatten te ontwikkelen. Daarnaast hebben we onlangs een ergonomisch mopsysteem geïntroduceerd, dat het werk voor onze medewerkers fysiek minder belastend maakt. Zulke verbeteringen hebben direct effect op de dagelijkse praktijk en juist dat maakt mij trots.
Als ik iets zou mogen veranderen in de cleanroomindustrie, dan is het de samenwerking en afstemming tussen cleanroommanagers, medewerkers en schoonmakers. Schoonmaak is een essentieel onderdeel van het proces, maar krijgt nog niet altijd de aandacht die het verdient. Door beter samen te werken en elkaar als volwaardige partners te zien, kunnen we de kwaliteit en continuïteit van cleanrooms naar een hoger niveau tillen. De rol van schoonmaak en schoonmakers verdient meer waardering en aandacht, met duidelijke protocollen, goede materialen en slimme hulpmiddelen. Denk bijvoorbeeld aan een digitale aftekenlijst waarmee problemen sneller opgespoord en opgelost kunnen worden. Op die manier kunnen we samen zorgen voor maximale kwaliteit, betrouwbaarheid en veiligheid. Bij Asito zetten we daar al concrete stappen in. Zo volgen diverse medewerkers momenteel een aanvullend programma waarin zij extra kennis opdoen over normeringen, protocollen en kwaliteitscontroles. Daarmee kunnen zij niet alleen hun werk beter uitvoeren, maar ook advies geven en als deskundigen worden gezien. Dat helpt niet alleen de sector vooruit, maar tilt ook onze eigen dienstverlening naar een hoger niveau.





Ben jij jonger dan 35 jaar, nieuwsgierig en actief in de wereld van contamination control? Dan is VCCN Young Professionals dé plek voor jou! Hier kun je je persoonlijke ontwikkeling een flinke boost geven, bijdragen aan de toekomst van het vakgebied én je netwerk van jonge vakgenoten flink uitbreiden.
WAAROM AANSLUITEN?
VCCN Young Professionals is speciaal opgericht voor jonge professionals die actief willen meedenken, leren en groeien binnen contamination control. Met VCCN Young Professionals vergroten we de betrokkenheid van jonge professionals en dragen we bij aan hun binding met het werkveld.
We organiseren inspirerende activiteiten, zoals:
• Excursies bij toonaangevende bedrijven
• Kennissessies over de nieuwste ontwikkelingen
• Presentaties en praktijkverhalen van experts
• Daarnaast stimuleren we actieve inbreng vanuit jonge professionals bij onze evenementen en zoeken we samenwerkingen met jongerenafdelingen van relevante verenigingen uit andere sectoren.
OP?
• Ontmoet andere jonge professionals die weten wat er speelt.
• Bouw een waardevol netwerk van jonge vakgenoten op.
• Ontdek de nieuwste trends en innovaties in contamination control.
• Laat je inspireren door praktijkverhalen en sprekers.
Extra voordeel: Als lid kun je ook (gratis) lid worden van het International Confederation of Contamination Control Societies (ICCCS) Young Professional programma. Dit is een internationaal netwerk van jonge contamination control-specialisten.
VOOR WIE IS HET?
Je kunt je aansluiten als je:
• werkzaam bent binnen Contamination Control en/of cleanliness.
• jonger bent dan 35 jaar.
• persoonlijk lid bent van VCCN.
INTERESSE?
Laat deze kans niet liggen! Word lid van VCCN Young Professionals, ontmoet gelijkgestemden, deel ervaringen, ontdek nieuwe kennis en geef jou carrière een boost.
Aanmelden kan via www.vccn.nl/vyp.












29 oktober 2025 | 10.30 tot 19.00 | Congrescentrum 1931, Den Bosch

Wil jij in één dag bijgepraat worden over de nieuwste inzichten, technieken en praktijkervaringen binnen contamination control en cleanroomtechnologie? Mis het VCCN Contamination Control Congres 2025 op woensdag 29 oktober in Den Bosch niet! Dit congres is interessant voor jou als beginnend en ervaren professional actief in de micro-elektrnica, life science, health care, food of space sector.
Tijdens dit congres kun je kiezen uit twee inspirerende programmalijnen met contamination control als rode draad.
In de eerste programmalijn maak je kennis met de herziening van VCCN Richtlijn 10: Classificeren en testen van luchtdoorlatendheid. Deskundigen die meewerken aan de herziening nemen je mee in de aanpassingen. Je hoort hier alles over nieuwe eisen, materialen, bouwmethoden en testprocedure, en ontdekt wat deze herziening betekent voor de praktijk. De tweede programmalijn richt zich op het ontwerpen, bouwen en beheren van cleanrooms en de toepassing van cleanroom technologie. Hier komen onderwerpen aan bod als actuele normen en richtlijnen, validatie en classificatie, cleaning en desinfectie en de toepassing van duurzaamheid in cleanroomtechnologie.
Beide programma’s sluiten af met een interactieve workshop, zodat je de opgedane kennis direct kunt vertalen naar de praktijk.
Naast de lezingen is er volop gelegenheid om elkaar te ontmoeten. Op de bedrijvenmarkt maak je kennis met de nieuwste innovaties en producten en tijdens het netwerkdiner is er ruimte om ideeën uit te wisselen en nieuwe samenwerkingen te starten.
Kortom: dit wil je niet missen. Zorg dat je erbij bent en meld je vandaag nog aan. We ontmoeten je graag op 29 oktober in Den Bosch!
Aanmelden via onze website:
Contamination Control Cursus Woerden
Cleanroom Reiniging Cursus Woerden
Cleanroom Schoonmaak Cursus Woerden
Opleiding Cleanroom Testen en CertificerenBelangstellenden en Associate Woerden
Opleiding Cleanroom Testen en CertificerenProfessional Woerden
Cleanroom Testing and Certify Course Education / Knowledge / Association Woerden
Cleanroom Testing and Certify Cours Professional Woerden
Cleanroom Gedrag Cursus Amersfoort
Cleanroom Gedrag Cursus Woerden
Cleanroom Reiniging Cursus Woerden
Cleanroom Schoonmaak Cursus Woerden
Cleanroom Techniek Cursus Woerden
Cleanroom Behaviour Course Woerden

Dyzle Services B.V.
Dyzle Services B.V. biedt gevalideerde temperatuurbewaking, EMS en temperatuurmapping voor organisaties met een GxP-vergunning. Onze oplossing is betrouwbaar en eenvoudig te gebruiken en ontwikkeld voor zowel technische als dagelijkse gebruikers. Wij zorgen dat u voldoet aan GxP-richtlijnen, met realtime inzicht en minimale inspanning. Alles wat wij leveren is in eigen beheer ontwikkeld. Zo houden we grip op kwaliteit, functionaliteiten en kosten. We helpen ruim 2.000 organisaties in Europa bij het realtime bewaken van geneesmiddelen en vaccins. Dyzle staat voor pragmatiek, betrouwbaarheid en partnerschap. Daarom zijn wij de specialist voor iedereen die zekerheid en gebruikersgemak wil combineren in een oplossing die klaar is voor de toekomst.
Apleona Netherlands B.V. Flight Forum 80-119 5657 DC EINDHOVEN www.apleona.com
Vrijstad Facility Services B.V. Nieuwe Rijksweg 68 H 4128 BN LEXMOND www.vrijstadfs.nl
Doeko
Thomas van Heereveldstraat 1 6551 AK WEURT www.doeko.nl
Data onder voorbehoud
Bezoek voor meer informatie www.vccn.nl
RM Precision B.V. Edisonstraat 7 7442 DB NIJVERDAL www.rmprecision.nl

Bij VCCN draait alles om het delen en ontwikkelen van kennis op het gebied van contamination control en product cleanliness. Als lid profiteer je van een breed aanbod aan activiteiten en publicaties die je helpen je kennis actueel te houden en je verder te ontwikkelen. Daarnaast krijg je de kans om actief bij te dragen aan de ontwikkeling van het vakgebied, bijvoorbeeld door deel te nemen aan commissies of projectgroepen.
VOORDELEN VAN HET LIDMAATSCHAP:
• Korting op alle VCCN-cursussen en workshops
• Korting op deelname aan evenementen en excursies
• 4x per jaar Contamination Control Magazine
• 4x per jaar het internationale vakblad CACR digitaal (Clean Air and Containment Review)
• Korting op technische rapporten, richtlijnen en boeken
Contamination control speelt in steeds meer vakgebieden een belangrijke rol. Binnen VCCN ontmoeten professionals met diverse achtergronden elkaar om kennis en ervaring te delen. Zo werken we gezamenlijk aan de continue verbetering van ons vakgebied.
Sluit je aan bij VCCN en werk mee aan de verdere ontwikkeling van het vakgebied.
Bekijk www.vccn.nl/word-lid voor meer informatie.
Jaargang 38
editie 3-2025
Contamination
Control Magazine is een uitgave van VCCN, Vereniging
Contamination Control
Nederland
REDACTIE
Philip van Beek
Arthur Lettinga
Jos Bijman
Thessa de Bree
REDACTIE COÖRDINATIE
Verenigingsbureau VCCN




T 088 - 401 06 50 j.bijman@vccn.nl
ADVERTENTIEVERKOOP













































Korenmolenlaan 4, 3447 GG Woerden









LIDMAATSCHAP VCCN



















































Kijk voor advertentietarieven op www.vccn.nl/c2mgzn of mail naar info@vccn.nl
Persoonlijk lidmaatschap € 52,50 per jaar (incl. btw)
Bedrijfslidmaatschap € 325,- per jaar (excl. btw)
FOTOVERANTWOORDING
Archief VCCN
VORMGEVING EN REALISATIE
Studio Campo
VERANTWOORDING
De realisatie van Contamination Control Magazine is zorgvuldig voorbereid, gepland en uitgevoerd. Desondanks kan VCCN geen verantwoordelijkheid aanvaarden voor eventuele onjuistheden.
COPYRIGHTS
Niets uit deze uitgave mag worden verveelvoudigd en/of openbaar worden gemaakt door middel van druk, microfilm of op welke andere wijze dan ook, zonder schriftelijke toestemming van de uitgever.










VCCN zorgt vanuit haar visie “We share the knowledge” voor het delen van kennis op het gebied van contamination control en cleanliness. Jaarlijks organiseren we hiervoor activiteiten zoals het Nationaal Symposium Contamination Control en het Contamination Control Congres. De technologische ontwikkelingen en procesinzichten binnen dit vakgebied volgen elkaar snel op en juist daarom is jouw inbreng onmisbaar.
Ben jij expert in een specifiek onderwerp, bijvoorbeeld op het gebied van wet- en regelgeving? Of wil je jouw enthousiasme over een nieuwe werkwijze of innovatie delen? VCCN biedt je graag een podium om jouw kennis en ervaring met vakgenoten te delen via een artikel in het Contamination Control Magazine of tijdens één van onze bijeenkomsten. We richten ieder symposium zo in dat alle interessevelden binnen VCCN aan bod komen. Denk hierbij aan:
• Food
• Health care
• Pharma
• Space
• Micro-nano
Binnen elk van deze velden spelen actuele ontwikkelingen rond wet- en regelgeving, werkwijzen, eisen en innovaties. Jouw bijdrage helpt vakgenoten hiervan op de hoogte te blijven.
De onderwerpen voor een lezing of artikel dienen binnen een van de interessevelden te vallen of hier direct mee te maken te hebben. Vermeld bij je abstract duidelijk voor welk veld jouw voorstel bedoeld is.
Alle inzendingen worden beoordeeld door de VCCN Commissie Lezingen & Conferenties. Daarbij letten we op de relevantie voor het vakgebied contamination control en de actualiteit binnen het gekozen interesseveld.
Wil je een abstract indienen? Neem dan contact op met: Jos Bijman, Kennismanager VCCN
E-mail: j.bijman@vccn.nl
Telefoonnummer: 088 - 4010 621



Met decennia lange ervaring in de cleanroom industrie, zorgen wij voor de beste oplossing voor uw cleanroom. Samen met u, identificeren wij uw behoeften en begeleiden wij u bij het gebruik van de correcte cleanroom kleding en accessoires.
Van het regelen van de voorraad, sterilisatie, levering, onderhoud tot vervanging.
U kan op ons rekenen!
Elis is een internationale multi-service provider voor cleanroom omgevingen met aanwezigheid in 18 landen en 3 continenten.


33 Cleanroom laundry solutions plants
We zorgen ervoor dat gereinigde cleanroomkleding, schoeisel, reinigingssystemen, en andere gerelateerde artikelen, elke dag gebruiksklaar zijn.
Onze artikelen voldoen aan de strengste normen en richtlijnen voor cleanroom omgevingen. Dankzij onze Quality Assurance afdeling zijn de cleanroom artikelen aantoonbaar risicovrij en klaar voor gebruik in uw productieproces.
We zorgen ervoor dat u het maximale kan bereiken.








